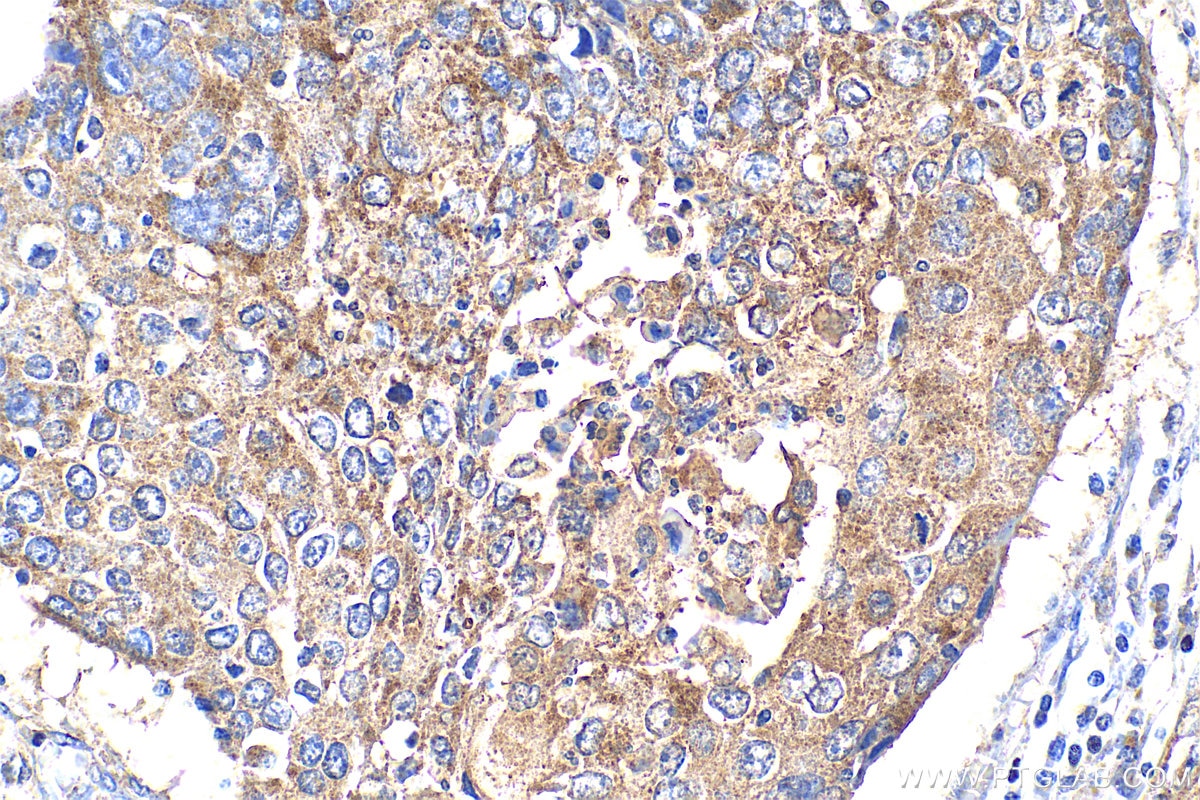
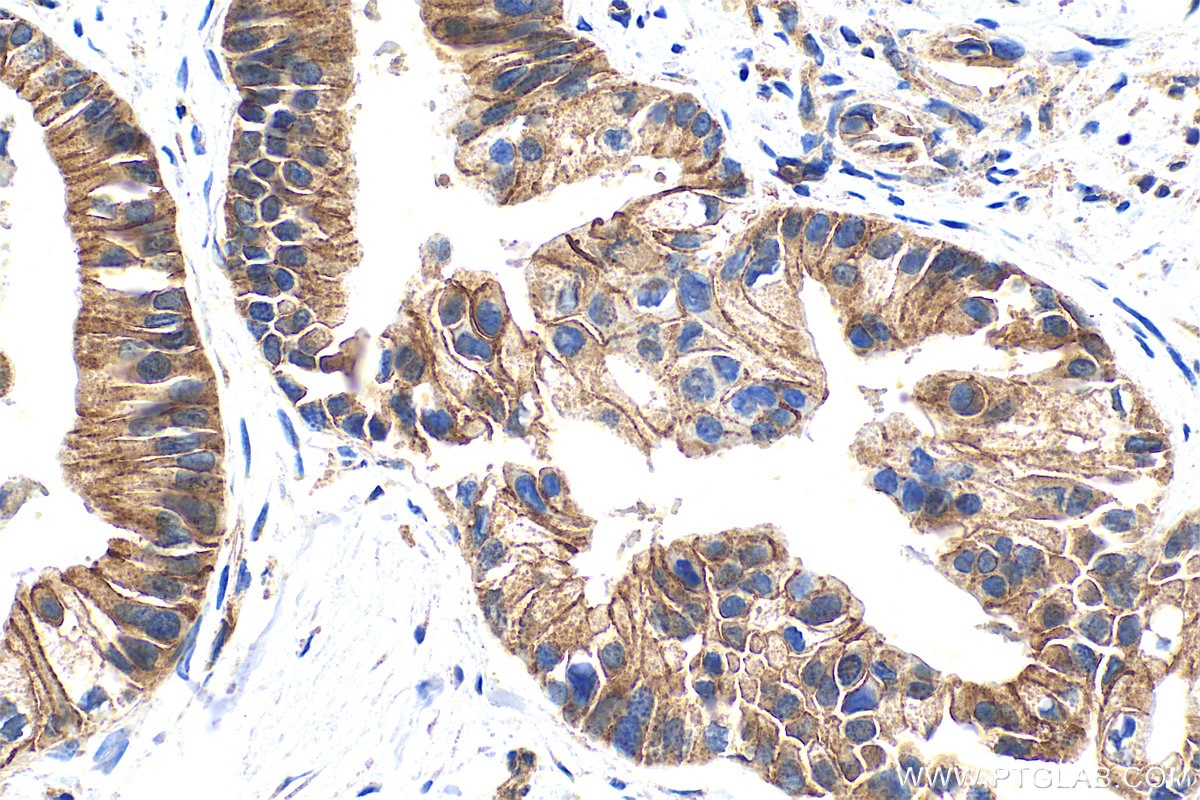

Tested Applications
| Positive WB detected in | NIH/3T3 cells, mouse brain tissue, rat brain tissue |
| Positive IHC detected in | human pancreas cancer tissue, human lung cancer tissue Note: suggested antigen retrieval with TE buffer pH 9.0; (*) Alternatively, antigen retrieval may be performed with citrate buffer pH 6.0 |
Recommended dilution
| Application | Dilution |
|---|---|
| Western Blot (WB) | WB : 1:500-1:2000 |
| Immunohistochemistry (IHC) | IHC : 1:200-1:800 |
| It is recommended that this reagent should be titrated in each testing system to obtain optimal results. | |
| Sample-dependent, Check data in validation data gallery. | |
Published Applications
| KD/KO | See 1 publications below |
| WB | See 36 publications below |
| IHC | See 4 publications below |
| IF | See 6 publications below |
Product Information
25900-1-AP targets ADAM10 in WB, IHC, IF, ELISA applications and shows reactivity with human, mouse samples.
| Tested Reactivity | human, mouse |
| Cited Reactivity | human, mouse, rat |
| Host / Isotype | Rabbit / IgG |
| Class | Polyclonal |
| Type | Antibody |
| Immunogen |
CatNo: Ag23078 Product name: Recombinant human ADAM10 protein Source: e coli.-derived, PET30a Tag: 6*His Domain: 306-512 aa of BC126253 Sequence: EQNHDDYCLAYVFTDRDFDDGVLGLAWVGAPSGSSGGICEKSKLYSDGKKKSLNTGIITVQNYGSHVPPKVSHITFAHEVGHNFGSPHDSGTECTPGESKNLGQKENGNYIMYARATSGDKLNNNKFSLCSIRNISQVLEKKRNNCFVESGQPICGNGMVEQGEECDCGYSDQCKDECCFDANQPEGRKCKLKPGKQCSTVCIQVKV Predict reactive species |
| Full Name | ADAM metallopeptidase domain 10 |
| Calculated Molecular Weight | 748 aa, 84 kDa |
| Observed Molecular Weight | 60-70 kDa, 90 kDa |
| GenBank Accession Number | BC126253 |
| Gene Symbol | ADAM10 |
| Gene ID (NCBI) | 102 |
| RRID | AB_2880291 |
| Conjugate | Unconjugated |
| Form | Liquid |
| Purification Method | Antigen affinity purification |
| UNIPROT ID | O14672 |
| Storage Buffer | PBS with 0.02% sodium azide and 50% glycerol, pH 7.3. |
| Storage Conditions | Store at -20°C. Stable for one year after shipment. Aliquoting is unnecessary for -20oC storage. 20ul sizes contain 0.1% BSA. |
Background Information
ADAM10, a member of the ADAM (a disintegrin and metalloprotease) family, is widely expressed in the brain, the spinal cord, and the visual system during development.MW of premature ADAM10 is 90 kDa and mature ADAM10 is 60-70 kDa (PMID: 24404179).
Protocols
| Product Specific Protocols | |
|---|---|
| IHC protocol for ADAM10 antibody 25900-1-AP | Download protocol |
| WB protocol for ADAM10 antibody 25900-1-AP | Download protocol |
| Standard Protocols | |
|---|---|
| Click here to view our Standard Protocols |
Publications
| Species | Application | Title |
|---|---|---|
Aging Cell Microglia-derived Galectin-9 drives amyloid-β pathology in Alzheimer's disease | ||
Cell Death Dis Cytoplasmic fragment of CD147 generated by regulated intramembrane proteolysis contributes to HCC by promoting autophagy. | ||
Pharmacol Res IDO1 can impair NK cells function against non-small cell lung cancer by downregulation of NKG2D Ligand via ADAM10. | ||
Cell Prolif Increased SPON1 promotes pancreatic ductal adenocarcinoma progression by enhancing IL-6 trans-signalling. | ||
J Neurosci Novel Social Stimulation Ameliorates Memory Deficit in Alzheimer's Disease Model through Activating α-Secretase | ||
Front Cell Dev Biol NLGN3 Upregulates Expression of ADAM10 to Promote the Cleavage of NLGN3 via Activating the LYN Pathway in Human Gliomas. |
Reviews
The reviews below have been submitted by verified Proteintech customers who received an incentive for providing their feedback.
FH Angelique (Verified Customer) (02-03-2025) | used in western-blot (o/n 4°C 1/1000) on mouse livers and liver tumors. Strong signal, few non-specific band
![]() |
FH Xiaoyu (Verified Customer) (02-07-2024) | Good signal
![]() |
FH David (Verified Customer) (09-02-2019) | Used for immunoblot at 1:1000 which gives good, clear bands at the expected molecular weight, but does require long exposure times (30µg total protein, 10-15 minutes exposure). 1:500 would probably be a better dilution and this will be used for future experiments. It can be difficult to obtain good ADAM10 antibodies, but after trying several, this is the best.
|